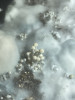
img-2118.jpg

Ciao a tutti,
Qualcuno sta coltivando con successo questa specie? Ovviamente partendo da 0
Sto cercando di riunire tutti i trucchi per creare una guida da condividere su psilocina.it.
Sono riuscito ad avere qualche frutto (davvero impressionanti) usando un mix di torba vermiculite e stallatico. Sicuramente esistono tek migliori e spero che qualcuno possa aiutarmi a migliorare 🙂